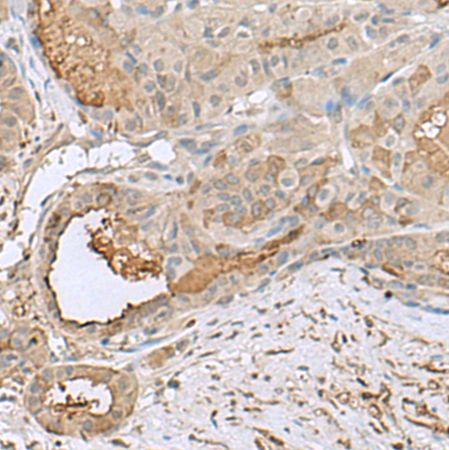
兔抗GABARAPL2多克隆抗体

相关产品推荐更多 >
万千商家帮你免费找货
0 人在求购买到急需产品
- 详细信息
- 技术资料
- 形态:
液体
- 保存条件:
冷冻(-20℃)避光
- 克隆性:
多克隆
- 适应物种:
兔
- 保质期:
一年
- 抗原来源:
GABARAPL2
- 库存:
200
- 供应商:
上海酶联生物科技有限公司
- 宿主:
Rabbit
- 应用范围:
仅供科研使用
- 抗体英文名:
Anti-GABARAPL2rabbitpolyclonalantibody
- 抗体名:
兔抗GABARAPL2多克隆抗体
- 规格:
100ul/200ul/25ul
| 规格: | 100ul | 产品价格: | ¥1560.0 |
|---|---|---|---|
| 规格: | 200ul | 产品价格: | ¥2500.0 |
| 规格: | 25ul | 产品价格: | ¥420.0 |
中文名称: 兔抗GABARAPL2多克隆抗体
英文名称: Anti-GABARAPL2 rabbit polyclonal antibody
别 名: GABA type A receptor associated protein like 2; ATG8; GEF2; ATG8C; GEF-2; GATE16; GATE-16
相关类别: 一抗
储 存: 冷冻(-20℃)
宿 主: Rabbit
抗 原: GABARAPL2
反应种属: Human, Mouse, Rat
标 记 物: Unconjugate
克隆类型: rabbit polyclonal
技术规格
| Background: | Ubiquitin-like modifier involved in intra-Golgi traffic. Modulates intra-Golgi transport through coupling between NSF activity and SNAREs activation. It first stimulates the ATPase activity of NSF which in turn stimulates the association with GOSR1 (By similarity). Involved in autophagy. Plays a role in mitophagy which contributes to regulate mitochondrial quantity and quality by eliminating the mitochondria to a basal level to fulfill cellular energy requirements and preventing excess ROS production. Whereas LC3s are involved in elongation of the phagophore membrane, the GABARAP/GATE-16 subfamily is essential for a later stage in autophagosome maturation. |
| Applications: | ELISA, IHC |
| Name of antibody: | GABARAPL2 |
| Immunogen: | Fusion protein of human GABARAPL2 |
| Full name: | GABA type A receptor associated protein like 2 |
| Synonyms: | ATG8; GEF2; ATG8C; GEF-2; GATE16; GATE-16 |
| SwissProt: | P60520 |
| ELISA Recommended dilution: | 5000-10000 |
| IHC positive control: | Human thyroid cancer |
| IHC Recommend dilution: | 40-200 |
风险提示:丁香通仅作为第三方平台,为商家信息发布提供平台空间。用户咨询产品时请注意保护个人信息及财产安全,合理判断,谨慎选购商品,商家和用户对交易行为负责。对于医疗器械类产品,请先查证核实企业经营资质和医疗器械产品注册证情况。
兔抗GABARAPL2多克隆抗体
¥420 - 2500